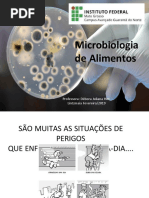

100% acharam este documento útil (2 votos)
350 visualizações24 páginasLegislação de Alimentos no Brasil
O documento discute a legislação de alimentos no Brasil. Ele explica que a legislação protege a saúde do consumidor, minimiza divergências entre produtores e consumidores e direciona as ações dos órgãos fiscalizadores. Também identifica os principais órgãos reguladores no Brasil, como a ANVISA e o MAPA, e discute resoluções importantes sobre padrões microbiológicos e matérias estranhas em alimentos.
Enviado por
OdaisaDireitos autorais
© © All Rights Reserved
Levamos muito a sério os direitos de conteúdo. Se você suspeita que este conteúdo é seu, reivindique-o aqui.
Formatos disponíveis
Baixe no formato PDF, TXT ou leia on-line no Scribd
100% acharam este documento útil (2 votos)
350 visualizações24 páginasLegislação de Alimentos no Brasil
O documento discute a legislação de alimentos no Brasil. Ele explica que a legislação protege a saúde do consumidor, minimiza divergências entre produtores e consumidores e direciona as ações dos órgãos fiscalizadores. Também identifica os principais órgãos reguladores no Brasil, como a ANVISA e o MAPA, e discute resoluções importantes sobre padrões microbiológicos e matérias estranhas em alimentos.
Enviado por
OdaisaDireitos autorais
© © All Rights Reserved
Levamos muito a sério os direitos de conteúdo. Se você suspeita que este conteúdo é seu, reivindique-o aqui.
Formatos disponíveis
Baixe no formato PDF, TXT ou leia on-line no Scribd